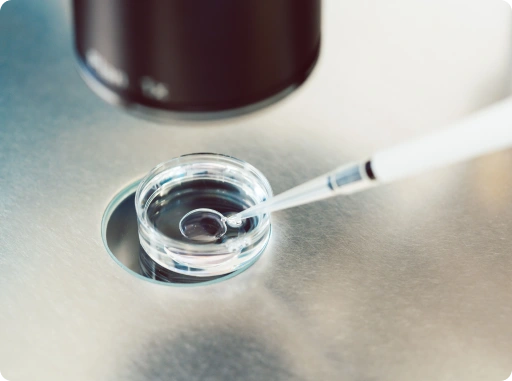
in vitro developmental biology

search
Jan 09, 2026
In vitro biology plays a pivotal role in modern research, providing a controlled environment for studying cellular, molecular, and developmental processes outside living organisms. From drug discovery & preclinical testing to plant studies in in vitro cellular & developmental biology, this approach allows scientists to generate reliable, reproducible data while minimizing reliance on animal models. Understanding the principles, techniques, and applications of in vitro biology methods is essential for advancing both basic and applied science.
Replicating biological processes in a controlled, artificial environment stands at the core of in vitro biology. Researchers culture cells, tissues, or organisms under precisely defined conditions, enabling them to monitor growth, differentiation, and molecular responses. By isolating variables, this approach makes it easier to study specific mechanisms without interference from whole-organism complexity. These foundational principles apply to both in vitro cellular and developmental biology and plant systems, supporting experiments that inform later in vivo studies.


In vitro biology methods rely on a variety of experimental techniques to study biological systems in a controlled environment. These include cell culture, where animal or plant cells are grown and maintained under precise conditions organ-on-a-chip systems, which simulate tissue- and organ-level function for drug testing and 3D culture and spheroids, which create more physiologically relevant tissue models. Researchers also use molecular assays to measure gene expression, protein function, and biochemical activity. Together, these approaches enable high-throughput analysis, mechanistic studies, and predictive modeling, making them essential in drug discovery & preclinical testing and in plant-focused in vitro developmental biology.

In vitro biology offers several key benefits:
Additionally, plant-focused in vitro developmental biology enables the study of growth, differentiation, and genetic modifications without environmental variability, accelerating agricultural and biotechnological research.


The field of in vitro biology continues to evolve, driven by technological advancements and the demand for more predictive and ethical research models. Emerging trends include integrating high-throughput screening and automation to accelerate drug discovery, using 3D bioprinting and organoid models to better replicate human physiology, and incorporating computational modeling and AI to enhance predictive accuracy. These innovations are expanding the reach of in vitro biology methods, making them increasingly central to research in medicine, pharmacology, and biotechnology.
In vitro refers to experiments performed outside a living organism, typically in a controlled lab environment.
In vitro biology allows researchers to study cellular and molecular processes precisely, reducing complexity and improving reproducibility.
In vitro methods provide critical data for drug discovery & preclinical testing, helping identify promising compounds and predict their behavior before animal or human studies.
